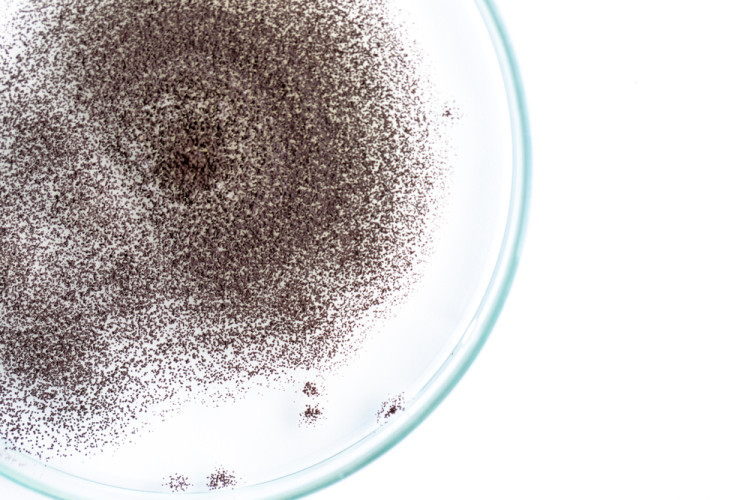
Welche Bedeutung haben Schimmelpilze in Lebensmitteln? Welche Bedeutung haben Schimmelpilze in Lebensmitteln?

News
22.10.2019 - Mikrobiologie
Welche Bedeutung haben Schimmelpilze in Lebensmitteln?
Steckbrief zu „Schimmelpilzen“
Allgemeines und Herkunft
Schimmelpilze sind in unserer Umwelt weit verbreitet (Erdboden, Pflanzen, Luft, Wasser, Menschen...) und deshalb in vielen Lebensmittel anzutreffen.
In pflanzlichen Lebensmitteln wie Getreideprodukten, Nüssen, Kräutern, Gewürzen, Gemüse und Obst treten Schimmelpilze regelmäßig auch in überhöhter Anzahl auf. Abgetrocknete Lebensmittel tierischer Herkunft wie Rohpökelware können ebenfalls vom Verderb durch Schimmelpilze betroffen sein.
Bedeutung
Je nach Lebensmittelgruppe wird eine bestimmte Anzahl von Schimmelpilzen in den meisten Lebensmitteln toleriert. Werden diese Werte jedoch überschritten, so deutet dies auf einen möglichen Verderb des Lebensmittels hin. Im Gegensatz zu den meisten Bakterien haben viele Schimmelpilze die besondere Eigenschaft auch noch bei niedrigen Wassergehalten und/oder niedrigen pH-Werten zu wachsen.
Von bestimmten Schimmelpilzen kann auch eine Gesundheitsgefahr für den Verbraucher ausgehen, da sie sehr giftige Mykotoxine (z. B. Aflatoxine, Ochratoxine, Fusarientoxine, Patulin, ...) bilden können. Verschimmelte Roh- und Zwischenprodukte dürfen nicht mehr weiterverarbeitet werden, da die Toxine teilweise sehr resistent (z. B. hitzeresistent) sind und Verarbeitungsprozesse überstehen können.
Wichtige Ursachen für eine überhöhte Anzahl
- Verarbeitung kontaminierter Rohstoffe
- unsachgemäße Lagerung (überhöhte Luftfeuchtigkeit bzw. Temperaturen, zu lange Lagerdauer…)
- hohe Anzahl von Schimmelpilzen in der Umgebungsluft (Lager, Produktionsstätte)
- mangelnde Produktionshygiene
Wachstumsbedingungen
- Temperatur: Wachstum bei 0 – 60 °C
- pH-Wert: Wachstum bei 3,0 – 7,0
- aw-Wert: Wachstum bis min. 0,62 – 0,85
- Sauerstoffbedarf: aerob; unter anaeroben Bedingungen können manche Schimmelpilze gären – das Wachstum wird jedoch in der Regel nach kurzer Zeit gehemmt
Bei welchen Temperaturen sterben diese Mikroorganismen ab?
Allgemein kann man davon ausgehen, dass die meisten Schimmelpilze bei einer Erhitzung auf +72 °C für mindestens zwei Minuten oder bei einem gleich wirksamen Prozess abgetötet werden. In Lebensmitteln ist dabei zu beachten, dass diese Temperatur-Zeit-Kombination im Kern des Produktes erreicht werden muss, um die Bakterien sicher abzutöten.
Allerdings ist zu beachten, dass es unter den Schimmelpilzen auch sehr hitzeresistente Vertreter gibt, die die oben genannte Temperatur-Zeit-Kombination überleben können.
Weitere Informationen und Literatur
- www.lgl.bayern.de: unter „Lebensmittel“ und anschließend „Hygiene“
- Lebensmittelmikrobiologie, J. Krämer und A. Prange, 7. Auflage 2017
- Merkblatt „Sicher verpflegt – Besonders empfindliche Personengruppen in Gemeinschaftseinrichtungen“, Bundesinstitut für Risikobewertung, Berlin 2017
- Mikroorganismen in Lebensmitteln, H. Keweloh, 2. Auflage 2008
In unserem Labor führen wir die Untersuchung auf Schimmelpilze regelmäßig durch. Wir liefern Ihnen schnelle und zuverlässige Ergebnisse.
Für Fragen stehen Ihnen unsere Kundenberater sehr gerne zur Verfügung.